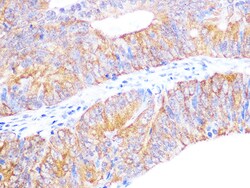
Invitrogen Cyclophilin 40 Recombinant Rabbit Monoclonal Antibody (4O7P5)

missing translation for 'onlineSavingsMsg'
Learn More
Learn More
Invitrogen™ Cyclophilin 40 Recombinant Rabbit Monoclonal Antibody (4O7P5)


Cyclophilin 40 Recombinant Rabbit Monoclonal Antibody (ARC1260)
Brand: Invitrogen™ MA535640
This item is not returnable.
View return policy
Description
Cyclophilin 40 Recombinant Monoclonal Antibody for Western Blot
This gene encodes a H1 histone binding protein that is involved in transporting histones into the nucleus of dividing cells. Multiple isoforms are encoded by transcript variants of this gene. The somatic form is expressed in all mitotic cells, is localized to the nucleus, and is coupled to the cell cycle. The testicular form is expressed in embryonic tissues, tumor cells, and the testis. In male germ cells, this protein is localized to the cytoplasm of primary spermatocytes, the nucleus of spermatids, and the periacrosomal region of mature spermatozoa.
Specifications
| Cyclophilin 40 | |
| Recombinant Monoclonal | |
| 0.67 mg/mL | |
| PBS with 0.05% BSA, 50% glycerol and 0.02% sodium azide; pH 7.3 | |
| Q08752, Q6DGG0, Q9CR16 | |
| PPID | |
| A synthetic peptide corresponding to a sequence within amino acids 271-370 of human Cyclophilin 40 (Q08752). | |
| 100 μL | |
| Primary | |
| Human, Mouse, Rat | |
| Antibody | |
| IgG |
| ELISA, Immunohistochemistry (Paraffin), Western Blot, Immunocytochemistry | |
| 4O7P5 | |
| Unconjugated | |
| PPID | |
| 40 kDa peptidyl-prolyl cis-trans isomerase; 40 kDa peptidyl-prolyl cis-trans isomerase D; 4930564J03Rik; cyclophilin 40; cyclophilin D; cyclophilin-40; Cyclophilin-related protein; Cyp 40; Cyp D; CYP40; CYP-40; CYPD; CYP-S1; cytoplasmic cyclophilin D; EC 5.2.1.8; I79_011990; MGC33096; peptidyl-prolyl cis-trans isomerase D; peptidylprolyl isomerase D; peptidylprolyl isomerase D (cyclophilin D); PPIase; PPIase D; PPID; Ppidl; Ppif; rotamase; Rotamase D; S-cyclophilin; SCYLP; testicular tissue protein Li 147 | |
| Rabbit | |
| Affinity chromatography | |
| RUO | |
| 361967, 5481, 67738 | |
| -20°C, Avoid Freeze/Thaw Cycles | |
| Liquid |
Product Content Correction
Your input is important to us. Please complete this form to provide feedback related to the content on this product.
Product Title
Spot an opportunity for improvement?Share a Content Correction